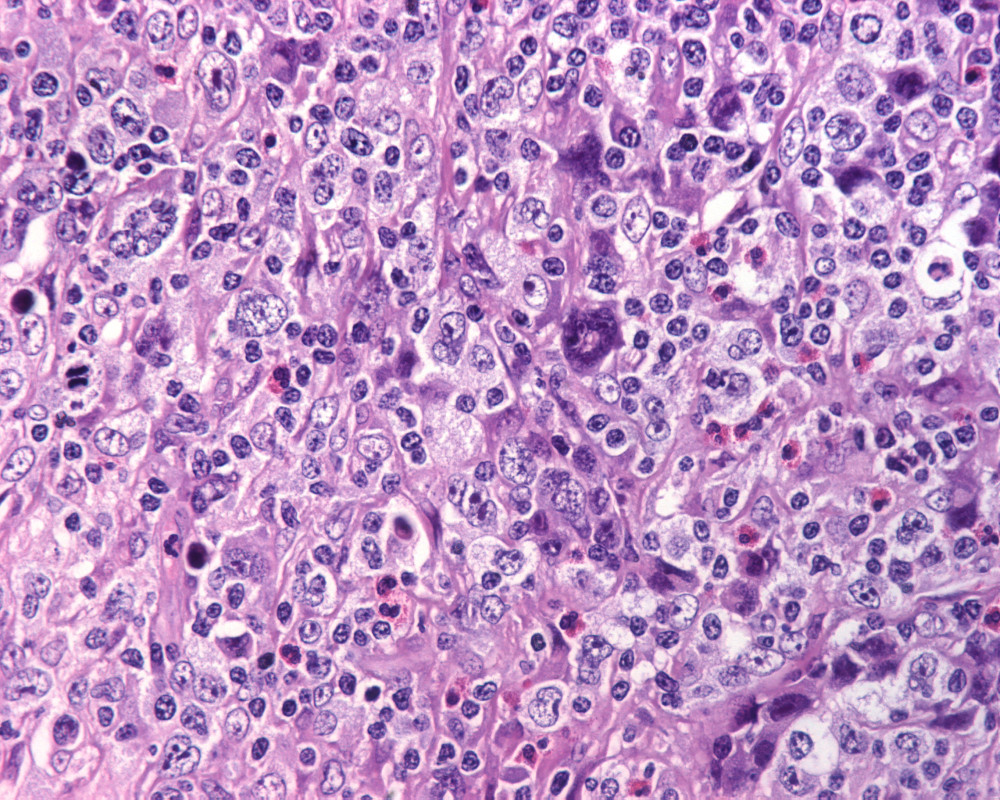
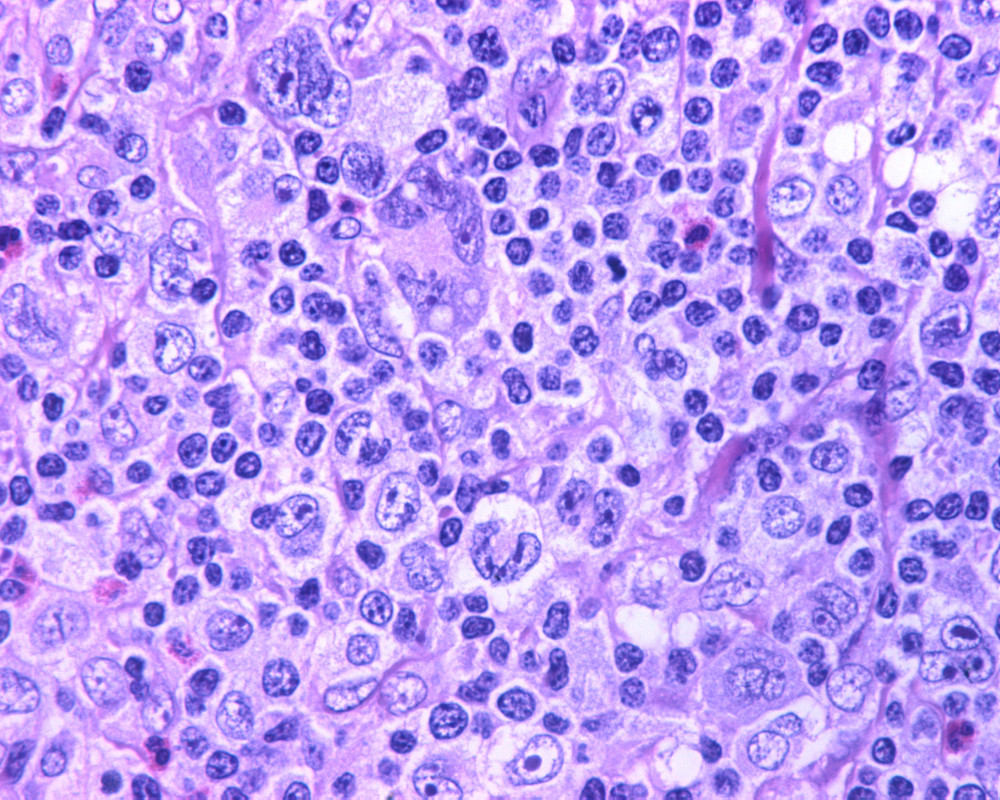
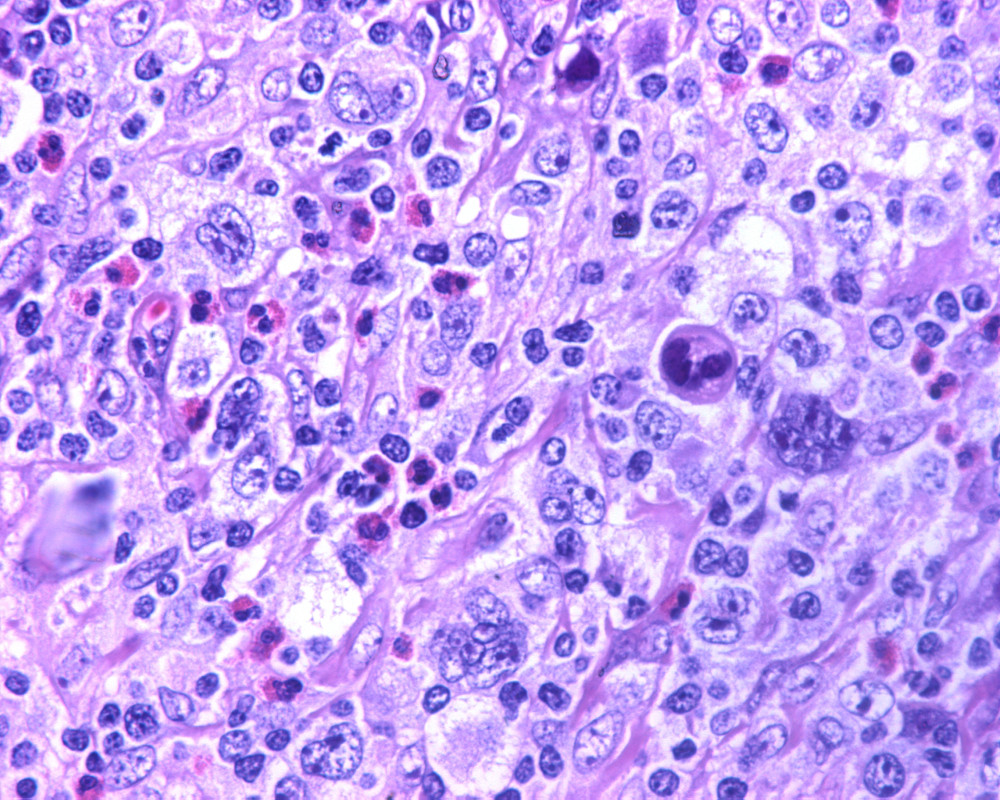
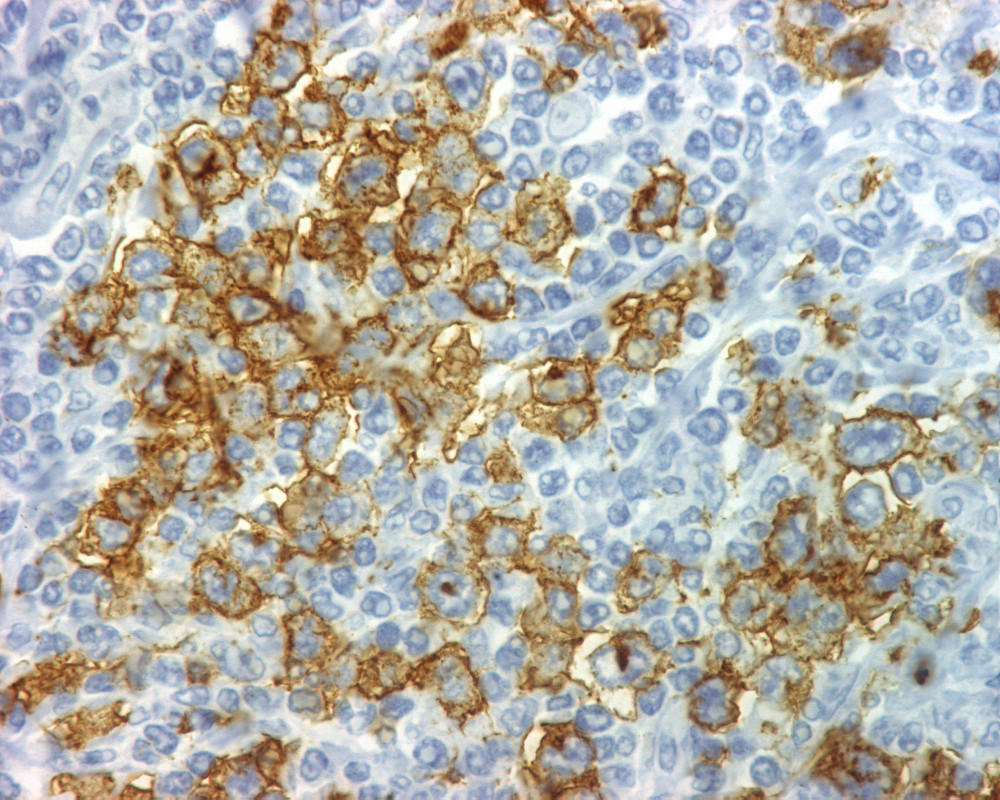

Mujer de 22 años con antecedente de linfoma multitratado, con recaídas y recidivas de la enfermedad. Ingresa en esta ocasión por la presencia de “síntomas B” y adenopatías cervicales.
A la EF: adenopatías cervicales bilaterales y hepato-esplenomegalia. Sus exámenes de laboratorio mostraron: Hb 10.6, leucocitos 5,180, NT 3720 y plaquetas 10, 002.
TAC

Biopsia de ganglio linfático.
Estudio de inmunohistoquímica
PREGUNTAS:
-¿Cuál es su diagnóstico de trabajo por morfología y su diferencial?
-¿Qué terapéutica propondría?

CD20

CD3
CD15

CD30

LMP1

OCT2

BOB-1

ALK-1

PDL1

PDL2
DIAGNÓSTICO: LINFOMA DE HODGKIN CLASICO, ESCLEROSIS NODULAR, VARIANTE SINCICIAL
BIBLIOGRAFIA
Ther Adv Hematol 2017, Vol. 8(1) 13 –20
Differences in outcome of patients with syncytial variant Hodgkin lymphoma compared with typical nodular sclerosis Hodgkin lymphoma
Tarsheen Sethi, Van Nguyen, Shaoying Li, David Morgan, John Greer and Nishitha Reddy
.
Trends in Immunology, May 2019, Vol. 40, No. 5
https://doi.org/10.1016/j.it.2019.03.003
Immunotherapy in relapsed refractory Hodgkin lymphoma. A chromosomal alteration present in almost all patients with Hodgkin lymphoma makes the disease uniquely vulnerable to PD-1/PD-L1 immune checkpoint blockers. Astrid Pavlovsky reviews the trial evidence and clinical experience, and looks to the future possible use of this class of therapy.
Winter 2017 / 2018 49